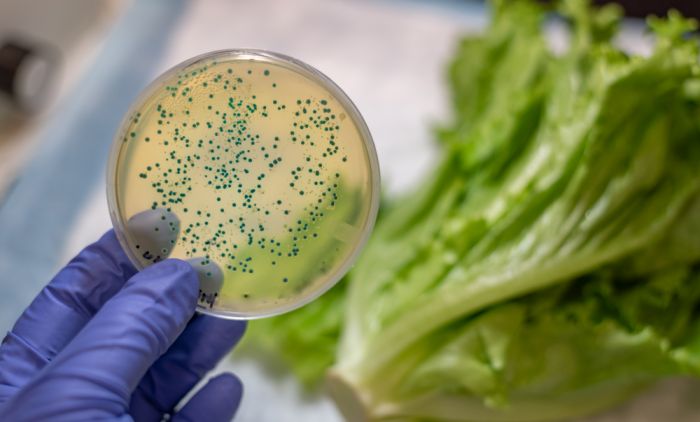

Ова бактерија нарушава здравља човека, углавном ремети флору црева, изазива инфекцију уринарног тракта или узрокује пнеумонију.
Ешерихија цоли је врста грам негативне бактерије штапићастог облика која након уласка у људски огранизам у највећем броју случајева има корисну улогу у раду система органа за варење. Ова батерија најчешће се уноси кроз контаминирану храну или пиће, посебно термисчки необрађено месо, али и воће и поврће.
Прочитајте још: Јабуково сирће крије бројне намене: Очистите њиме кућу, негујте кожу, а ево како да га користите за љубимце!
Сваки пацијент који се суочава са инфекцијом узрокованом понашањем бактерије Есцхерицхиа цоли добиће препоруке од лекара како да уведе промене у начин исхране да би терапија била успешна. Узимање медикамената неће помоћи у елиминацији микроорганизма у случају неправилног одабира хране.
Прочитајте још: Планирате ДИЈЕТУ? Ово су најгора три дана за почетак која ГАРАНТУЈУ НЕУСПЕХ
Доносимо вам један рецепт за доручак, који ће допренти бржем и лакшем уклањању ешерихије из ашег организма.
Кајгана са козјим сиром
Умутити виљушком два јајета и додати 30г козјег сира, а затим зачинити са мало соли и млевеног црног бибера. Испећи на пола кашике квалитетног путера и додати мало сецканог влашца.
Прочитајте још: Помаже код надутости, добар је за јетру, а може помоћи и при мршављењу...Зашто је још добро пити чај од маслачка?
Обиље витамина А, као и других корисних елемената за борбу против инфекције ешерихијом коли, чине козји сир одличном и веома здравом намирницом за заштиту и опоравак тела од бактерије.
Веома се лако вари и нутријети се тиме брзо апсорбују и користе унутар организма. Може се додавати и у главна јела и у прилоге.
Пратите нас на ИНСТАГРАМУ и ФЕЈСБУКУ






























